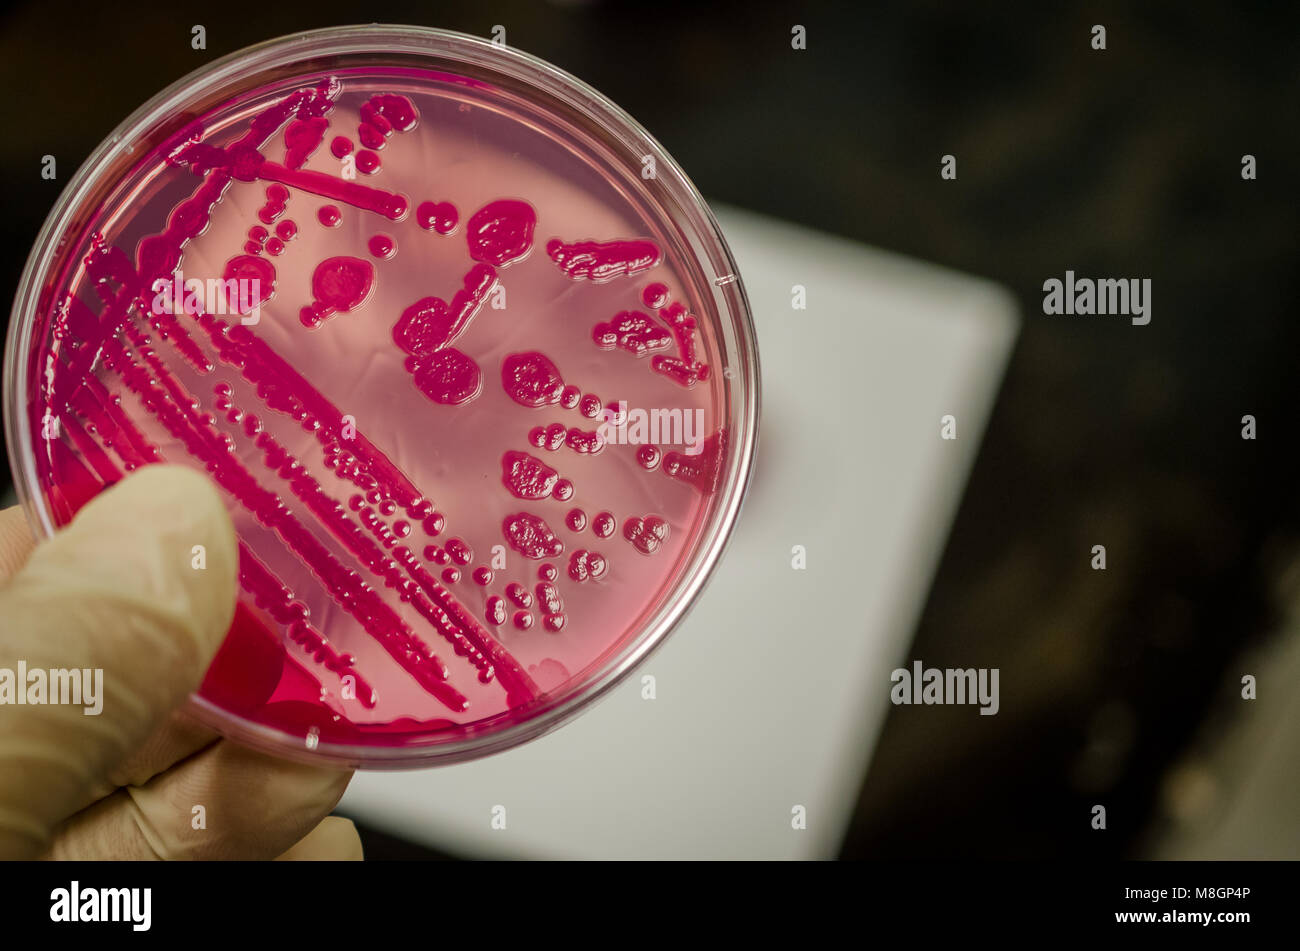
Coltura batterica piastra tenendo a portata di mano Foto Stock
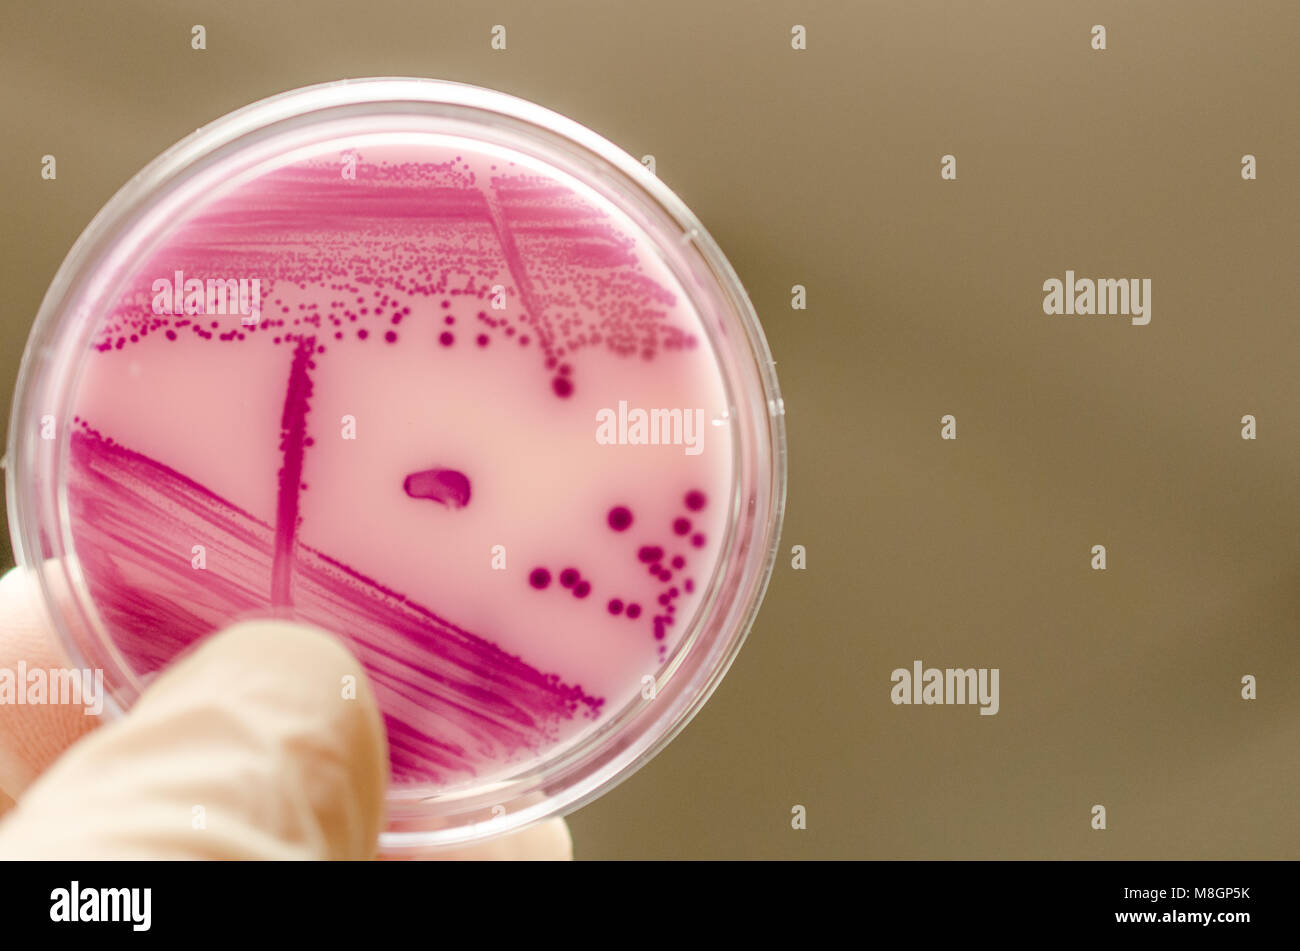
Coltura batterica piastra tenendo a portata di mano Foto Stock
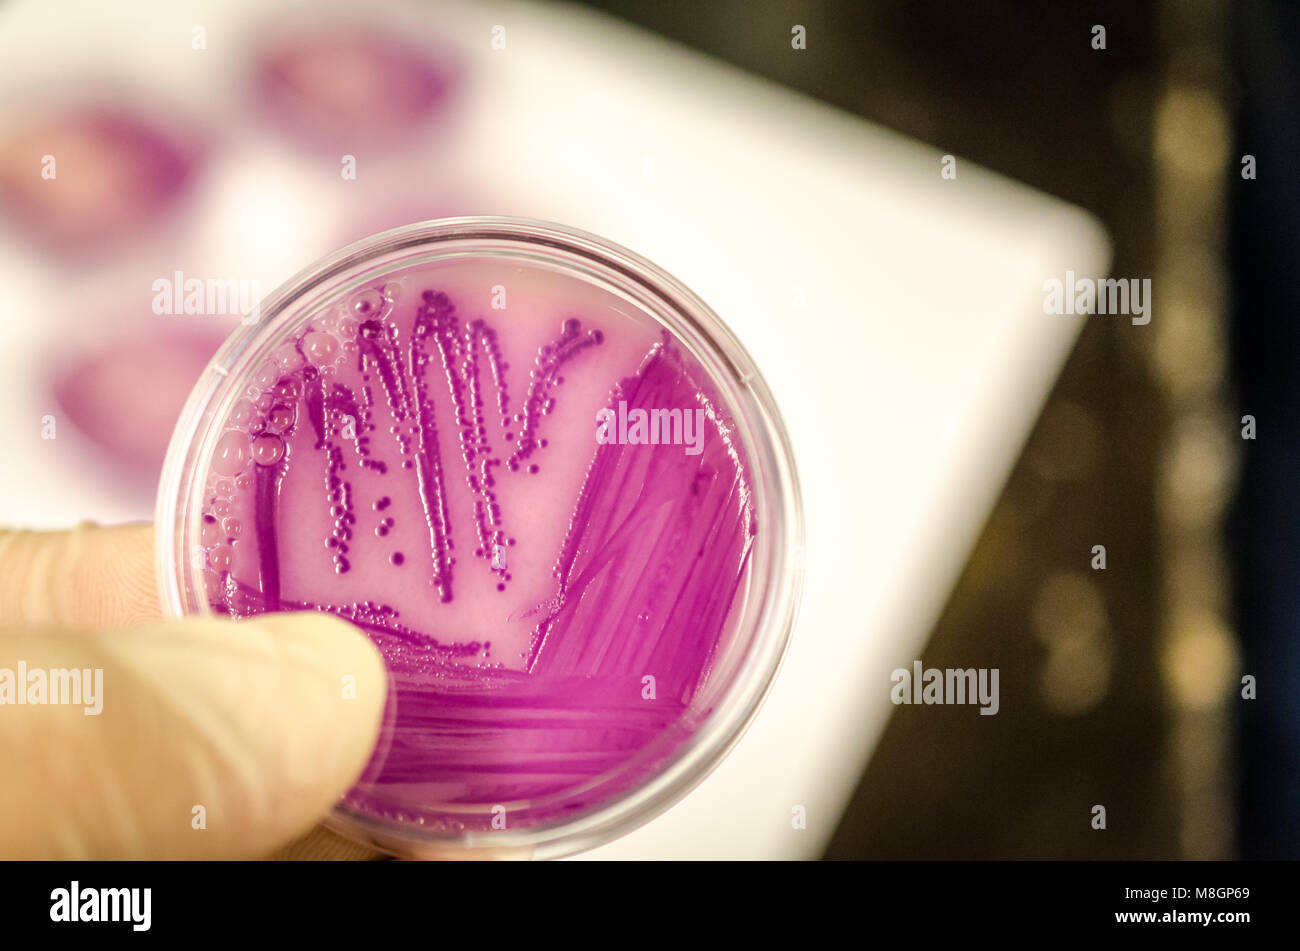
Coltura batterica piastra tenendo a portata di mano Foto Stock

Sviluppo di farmaci Immagini Stock
(28,695)Filtri rapidi:
Sviluppo di farmaci Immagini Stock

RF2BTP516–Donna ricercatrice che svolge ricerche scientifiche in un laboratorio di chimica, sviluppo di farmaci

RF2E1J6B0–Lo scienziato di laboratorio utilizza la micropipetta mentre esamina il campione che sta sviluppando il farmaco. Chimico in laboratorio moderno che fa la ricerca usando il dispenser durante l'epidemia globale con covid-19.
RF2J7XTD3–Medico donna irriconoscibile farmacista che indossa guanti di lattice che tengono la siringa e il flacone di covid 19 liquido vaccino rimedio cura farmaco preparazione per

RFM6MGHG–Medical Research Scientist digitando le informazioni ottenute dal nuovo farmaco sperimentale di prova. Lavora in un ambiente luminoso e moderno laboratorio.

RF2F9FBG9–Giovane donna in un laboratorio farmacologico. Sviluppo e ricerca di farmaci antiallergici

RM2WX3KGG–Sutton London, marzo 27 2024, Centre for Cancer Drug Development at Institute of Cancer Research with No People

RF2K2XDYM–Capsule antivirali con virus su sfondo blu. Sviluppo di nuovi farmaci e ricerca di nuovi farmaci per il trattamento delle malattie infettive emergenti. Farmaci da prescrizione. Industria farmaceutica. Farmacologia.
RF2WFR34P–Medici e dirigenti irriconoscibili stanno unendo le forze nello sviluppo e nella produzione di farmaci. Concetto per la scoperta di farmaci, contratto farmaceutico manu

RF2FWMDY9–Cellulare con logo aziendale della società di biotecnologia Wuxi Biologics (Cayman) Inc. Sullo schermo davanti al sito web. Mettere a fuoco il centro del display del telefono.

RF2DW0JAG–Manopola di rotazione manuale per selezionare le fasi della sperimentazione clinica del vaccino. Concentrarsi sulla fase di sorveglianza post-marketing. Immagine composita tra una fotografia a mano An

RF3CJ291M–Logo Eli Lilly segno della casa farmaceutica. Primo piano della segnaletica sull'esterno di un edificio per uffici. American Drug Development Corporation.

RM2JKFTF4–Un modello computerizzato di un complesso macromolecolare. Gli scienziati del National Institute on Drug Abuse (NIDA), parte del NIH, hanno scoperto complessi macromolecolari che potrebbero consentire lo sviluppo di farmaci. Lo studio cambia i concetti di decodifica cellulare a lungo termine.

RF2WY0529–Sartorius azienda edile, industria biofarmaceutica e laboratorio, sviluppo di farmaci, attrezzature di laboratorio e farmaceutiche, società tedesca Hea

RF2W8RE1K–Intelligenza artificiale delineata da varie pillole, che mostrano la miscela di prodotti farmaceutici con l'innovazione tecnologica artificiale intelligente. Pillole multicolore.

RM3CY0X7T–Ingresso della sede centrale di Richter Gedeon a Budapest, una delle principali aziende farmaceutiche dell'Europa centrale.

RFM6MG86–Team di Ricerca gli scienziati che lavorano con Personal Computer, analisi di test di prova di nuova generazione dati di farmaco. Essi lavorano in un moderno laboratorio

RF2FMGGC6–Giovane donna in un laboratorio farmacologico. Sviluppo e ricerca di farmaci antiallergici

RM2WX3KJ2–Sutton London, marzo 27 2024, Centre for Cancer Drug Development at Institute of Cancer Research with No People

RF2K2RXTE–Capsule antivirali con virus su sfondo blu. Sviluppo di nuovi farmaci e ricerca di nuovi farmaci per il trattamento delle malattie infettive emergenti. Farmaci da prescrizione. Industria farmaceutica. Farmacologia.

RF2S9FT6R–Capsule colorate pillola mostrano diversità antibiotica. Crescente preoccupazione per la resistenza agli antibiotici. Necessità urgente di sviluppare nuovi farmaci e adeguati

RF3CJK51N–Logo del marchio Eli Lilly Company sullo schermo con grafico grafico delle prestazioni finanziarie in magazzino sullo sfondo

RF2SP6AG9–Una persona che indossa un guanto blu sta tenendo una fiala trasparente in un laboratorio sterile, evidenziando la preparazione per le procedure mediche.

RF2E94K21–Persona che detiene il cellulare con il logo della società tedesca di biotecnologia MorphoSys AG in esposizione con la pagina web aziendale. Mettere a fuoco lo schermo del telefono.

RF2WH61CT–Colorata pila di pillole medicinali e globo. Copia spazio per il testo. Concetto medico e sanitario.

RF2PKK43Y–Una piccola scatola di metallo usata come scatola delle pillole su una superficie di marmo rosa

RF3BF5X9B–Sistemi mimetici patogeni. Utilizzo di cellule coltivate per imitare il comportamento patogeno per lo sviluppo di farmaci e studi di risposta immunitaria. Tecnologie per colture cellulari.

RF2WY052A–Sartorius azienda edile, industria biofarmaceutica e laboratorio, sviluppo di farmaci, attrezzature di laboratorio e farmaceutiche, società tedesca Hea

RF2GH6GTJ–Una serie di provette NMR pulite in un becher in un laboratorio di chimica per la ricerca biotecnologica per lo sviluppo di farmaci

RF3D5N4BA–Scrittura a mano "Clinical Trials" su una pila di note adesive accanto a uno stetoscopio, illustrando la ricerca medica e lo sviluppo di farmaci

RFM6MG7T–Team di Ricerca gli scienziati che lavorano con Personal Computer, analisi di test di prova di nuova generazione dati di farmaco. Essi lavorano in un moderno laboratorio

RF2FMGGC3–Giovane donna in un laboratorio farmacologico. Sviluppo e ricerca di farmaci antiallergici

RM3D3B8XB–New York, USA - 7 gennaio 2025: Sito Web Eledon Pharmaceuticals visualizzato sullo schermo del computer che mostra soluzioni biotecnologiche e sviluppo di farmaci

RF2K2BJ99–Vista dall'alto capsule pills su sfondo rosa. Farmaci da prescrizione. Capsule blu pillole. Industria farmaceutica. Medicamento e farmacologia. Sviluppo di farmaci e ricerca di nuovi farmaci. Capsule pills industria.

RF3BC8R0W–Blocchi colorati che formano un grafico a barre che mostra i benefici e gli effetti collaterali dei farmaci. Industria farmaceutica e test di sviluppo di farmaci.

RF3CKGATT–Lente per microscopio con illustrazione digitale di capsule, molecole e grafica chimica, simbolo della ricerca farmaceutica, dello sviluppo di farmaci, h

RF2GMN6HA–Pillola blu-bianca su sfondo giallo. Banner farmacia. Capsule pills industria di produzione. Industria farmaceutica. Sviluppo di farmaci.

RF2G24GDY–Le mani in guanti di gomma gialla tengono una provetta con un liquido verde. Sviluppo di nuovi farmaci, esperimento chimico. Laboratorio medico.

RF2E48G6N–Persona che detiene smartphone con logo aziendale della società tedesca di biotecnologia Evotec AG in esposizione davanti al sito web. Mettere a fuoco lo schermo del telefono cellulare.

RF2BTP3E9–Donna ricercatrice che svolge ricerche scientifiche in un laboratorio di chimica, sviluppo di farmaci

RF2WH61D2–Colorata pila di pillole medicinali e globo. Copia spazio per il testo. Concetto medico e sanitario.

RF2NDH8DY–Un beccuccio allungato in acciaio inossidabile lucido che spara un flusso d'acqua in una piscina termale

RF3BNYXDH–Pseudonocardia sp. actinomicete che produce antibiotici. Produce composti bioattivi per lo sviluppo di farmaci.

RF2WY052B–Sartorius azienda edile, industria biofarmaceutica e laboratorio, sviluppo di farmaci, attrezzature di laboratorio e farmaceutiche, società tedesca Hea

RF2GE04PX–Vari reagenti colorati in fiale di vetro su luce UV in un laboratorio di biotecnologia per esperimenti farmaceutici per lo sviluppo di farmaci
RF2WG05K2–Scienziato farmaceutico irriconoscibile che attiva un'applicazione basata sull'intelligenza artificiale per accelerare il processo di scoperta dei farmaci. Concetto del settore farmaceutico per la fornitura di piombo

RFM6MG8F–Ricerca di donne scienziato utilizza micropipetta riempire le provette per la prova in un grande e moderno laboratorio. Sullo sfondo gli scienziati stanno lavorando.

RF2FKY42C–Giovane donna in un laboratorio farmacologico. Sviluppo e ricerca di farmaci antiallergici

RM3D3W7BF–New York, USA - 26 gennaio 2025: Sito Web Medpace visualizzato sullo schermo di un laptop, che mostra i servizi di ricerca clinica e sviluppo di farmaci

RF2K27PFC–Vista dall'alto capsule pills su sfondo rosa. Farmaci da prescrizione. Capsule blu pillole. Industria farmaceutica. Medicamento e farmacologia. Sviluppo di farmaci e ricerca di nuovi farmaci. Capsule pills industria.

RF2F27DA1–Gaithersburg, MD, USA 01-29-2020: Vista esterna della sede centrale statunitense della società farmaceutica biomedica AstraZeneca . AstraZeneca con Università

RMJ3JY8H–Industria farmaceutica, servizi di analisi farmaceutica globale, il processo di sviluppo di farmaci, (Copyright foto © Saji Maramon)

RF2G1C22G–Capsule blu compresse sparse fuori del flacone su sfondo blu. Industria farmaceutica. Sviluppo di farmaci e nuove ricerche di farmaci per il trattamento emergente

RF2EHNY12–Telefono cellulare con pagina web della società americana Biogen Inc. Biotecnologia su schermo davanti al logo aziendale. Mettere a fuoco in alto a sinistra del display del telefono.

RF2BTP2XY–Donna ricercatrice che svolge ricerche scientifiche in un laboratorio di chimica, sviluppo di farmaci

RF2WY0520–Sartorius azienda edile, industria biofarmaceutica e laboratorio, sviluppo di farmaci, attrezzature di laboratorio e farmaceutiche, tedesco cCorporate HE

RF2GE04R3–Vari reagenti colorati in fiale di vetro su luce UV in un laboratorio chimico per esperimenti sanitari per lo sviluppo di farmaci

RM2JKFTM4–Immagine speculare di un cervello di topo con malattia neurodegenerativa di tipo Niemann-Pick C1 (NPC1). Un modo importante per valutare l'impatto di un potenziale terapeutico sul sistema nervoso centrale è quello di valutare la patologia cerebellare nei topi. I ricercatori del National Institute of Child Health and Human Development (NICHD) di Eunice Kennedy Shriver hanno scoperto che un farmaco sperimentale può stabilizzare o rallentare la progressione del NPC1.

RFM6MG8T–Ricerca di donne scienziato utilizza micropipetta riempire le provette per la prova in un grande e moderno laboratorio. Sullo sfondo gli scienziati stanno lavorando.

RF2FEJP2F–Giovane donna in un laboratorio farmacologico. Sviluppo e ricerca di farmaci antiallergici

RM3D34706–New York, USA - 26 gennaio 2025: Sito Web Medpace visualizzato sullo schermo di un laptop, che mostra i servizi di ricerca clinica e sviluppo di farmaci

RF2EAHXXW–Vista dall'alto pillole di capsule colorate. Pila completa di pillole di capsule di colori brillanti. Industria farmaceutica. Prodotti farmaceutici per l'assistenza sanitaria. Concetto di sviluppo dei farmaci. Bilancio e politica sanitaria.

RF2F27D9B–Gaithersburg, MD, USA 01-29-2020: Vista esterna della sede centrale statunitense della società farmaceutica biomedica AstraZeneca . AstraZeneca con Università

RF2H61D56–Gli scienziati maschili che lavorano allo sviluppo di un nuovo farmaco nel laboratorio di prodotti farmaceutici moderni.

RF2F531MA–Capsule blu su sfondo blu. Banner farmacia online. Gruppo delle pillole della capsula. Industria farmaceutica. Sviluppo di nuovi farmaci e ricerca di nuovi farmaci

RF2F0D0WC–Persona che detiene il cellulare con il logo della società sudafricana Aspen Pharmacare Holdings Ltd sullo schermo davanti alla pagina web. Mettere a fuoco il display del telefono.

RF2XD04K8–Sartorius azienda edile, industria biofarmaceutica e laboratorio, sviluppo di farmaci, attrezzature di laboratorio e farmaceutiche, sede aziendale tedesca

RF2GH6GTT–Varie provette NMR pulite in un becher in un laboratorio di chimica per la ricerca biotecnologica per lo sviluppo di farmaci